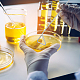
Распорка из нержавеющей стали 304 для ячейки STAS-WH0044-32P-5

- 0
- 0
- Days
- 0
- 0
- :
- 0
- 0
- :
- 0
- 0
Описание
Распорка из нержавеющей стали 304 для ячейки,лабораторные принадлежности,треугольные,цвет нержавеющей стали
Размер : шириной около 30.5 мм ,218 мм длиной,35 мм высотой,внутренний диаметр: 29x29 мм.
Цена указана за 10 шт.
Пожалуйста, обратите внимание: Небольшие отклонения в цветах возможны из-за различий в устройствах отображения.

iOS APP
iOS APP Google Play
Google Play
